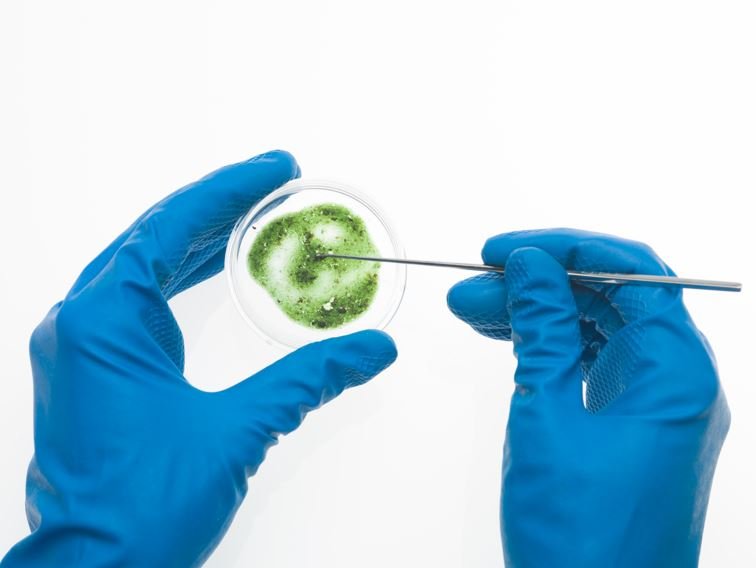
lab hands with mold dish

How Hidden Mold Exposure Impacts Your Genes and Immune System
Silver Genetics Works With Mycotoxins and Chronic Illness
Chronic illness can feel like a puzzle with missing pieces. Symptoms linger, flare, and shift without clear explanation, leaving people frustrated and searching for answers. One piece of that puzzle that is often overlooked is mold exposure. Not the visible mold you might see on food or walls, but microscopic toxins produced by mold called mycotoxins. These toxic compounds can accumulate in the body, disrupt immune function, and interact with genetic vulnerabilities in ways that make chronic illness worse. Understanding how mycotoxins influence health is critical for anyone dealing with long-term unexplained symptoms, particularly those linked to autoimmune disorders, chronic fatigue, or neurological changes.
What Are Mycotoxins?
Mycotoxins are toxic chemicals produced by certain molds as part of their survival process. Unlike the mold spores themselves, which can trigger allergic reactions, mycotoxins can cause direct toxic effects in the body. They are invisible, odorless, and can be present even when mold growth is hidden behind walls, under floors, or inside HVAC systems.
These toxins are resilient. They can contaminate food, water-damaged buildings, and even the air you breathe. Once inside the body, they accumulate in tissues and can be difficult to eliminate, particularly if detoxification pathways are compromised.
Common Sources of Exposure
Most people associate mold exposure with water-damaged homes, and this is indeed one of the biggest risk factors. However, exposure can also come from:
Contaminated food such as grains, nuts, and coffee beans.
Workplaces or schools with water damage.
Cars or boats with leaks or poor ventilation.
Hidden contamination in ventilation systems.
Because mycotoxins are not always visible, people often live in environments where exposure continues for months or years without detection.
How Mycotoxins Affect the Body
Once inside the body, mycotoxins can disrupt multiple systems. Research shows that these toxins:
Suppress immune system function, making it harder to fight infections.
Increase chronic inflammation that damages tissues and worsens autoimmune symptoms.
Interfere with mitochondrial energy production, leading to fatigue and brain fog.
Contribute to oxidative stress that harms cells and DNA.
Disrupt hormone balance, which can impact mood, fertility, and metabolism.
The effects vary depending on the type of mycotoxin, the level of exposure, and the genetic resilience of the individual.
The Gene-Mycotoxin Connection & Why Mycotoxin Illness Is Often Missed
Not everyone exposed to mold becomes sick. Two people can live in the same environment and have very different responses. This difference often comes down to genetics.
Certain genetic variations can influence:
Detoxification pathways: Some people have reduced ability to metabolize and eliminate toxins. When detox genes are less efficient, mycotoxins can build up in tissues, leading to chronic illness.
Immune regulation: Variations in immune system genes may cause overreactions to mold exposure or leave the immune system unable to clear toxins effectively.
Inflammatory responses: Genes that affect cytokine production can influence how strongly the body reacts to toxins, leading to prolonged inflammation.
Antioxidant defenses: Variants in genes related to antioxidant enzymes can reduce the ability to neutralize oxidative stress triggered by mycotoxins.
When genetic vulnerabilities and toxin exposure overlap, the risk of developing chronic illness increases dramatically.
Traditional medicine does not always test for mold exposure. Bloodwork may come back normal, leaving patients feeling dismissed or told that their illness is stress-related. Without specialized testing, mycotoxins can remain hidden contributors to poor health.
This is where genetic testing becomes an important tool. By identifying genetic weaknesses in detoxification and immune regulation, practitioners can connect the dots between environmental exposure and unexplained symptoms. Instead of chasing isolated complaints, a more complete picture of root causes begins to emerge.
Genetic testing offers valuable insight into how your body responds to toxins.
Genetic testing offers valuable insight into how your body responds to toxins. For example:
If your detoxification genes are sluggish, supporting liver and kidney pathways becomes essential.
If your antioxidant defenses are weak, targeted supplementation can reduce oxidative stress.
If immune regulation is compromised, addressing inflammation at the genetic level can improve resilience.
This information allows for personalized treatment strategies rather than one-size-fits-all protocols. Patients can stop guessing which detox programs, diets, or supplements might help and instead follow a plan informed by their unique biology.
Healing from mycotoxin illness involves two key steps: removing exposure and supporting the body’s recovery.
Identify and Eliminate Exposure
Professional mold inspection and remediation are crucial for anyone living in a contaminated environment. Simply masking the problem with air purifiers or cleaning visible mold is not enough if hidden growth remains.Support Detoxification Pathways
Based on genetic insights, targeted support may include specific nutrients, binding agents, or therapies that help the body eliminate toxins more effectively.Rebuild Immune and Mitochondrial Health
Strategies may include anti-inflammatory nutrition, mitochondrial support supplements, and therapies that calm overactive immune responses.Address Nutritional Needs
Because mold toxins can interfere with nutrient absorption, replenishing deficiencies with the right forms of vitamins and minerals can restore balance.
Bringing It All Together
Mycotoxins represent an invisible but powerful threat to health. While not everyone exposed to mold becomes sick, those with genetic vulnerabilities are more likely to experience severe and lingering symptoms. By combining environmental assessment with genetic testing, it becomes possible to uncover hidden contributors to chronic illness and design a path forward.
“Instead of continuing a cycle of unexplained fatigue, brain fog, and inflammation, patients can finally connect their symptoms to underlying causes. With the right support, the body can begin to recover, resilience can be restored, and life can feel more vibrant again. Silver Genetics can help.” - Dr. Dennis Hooper